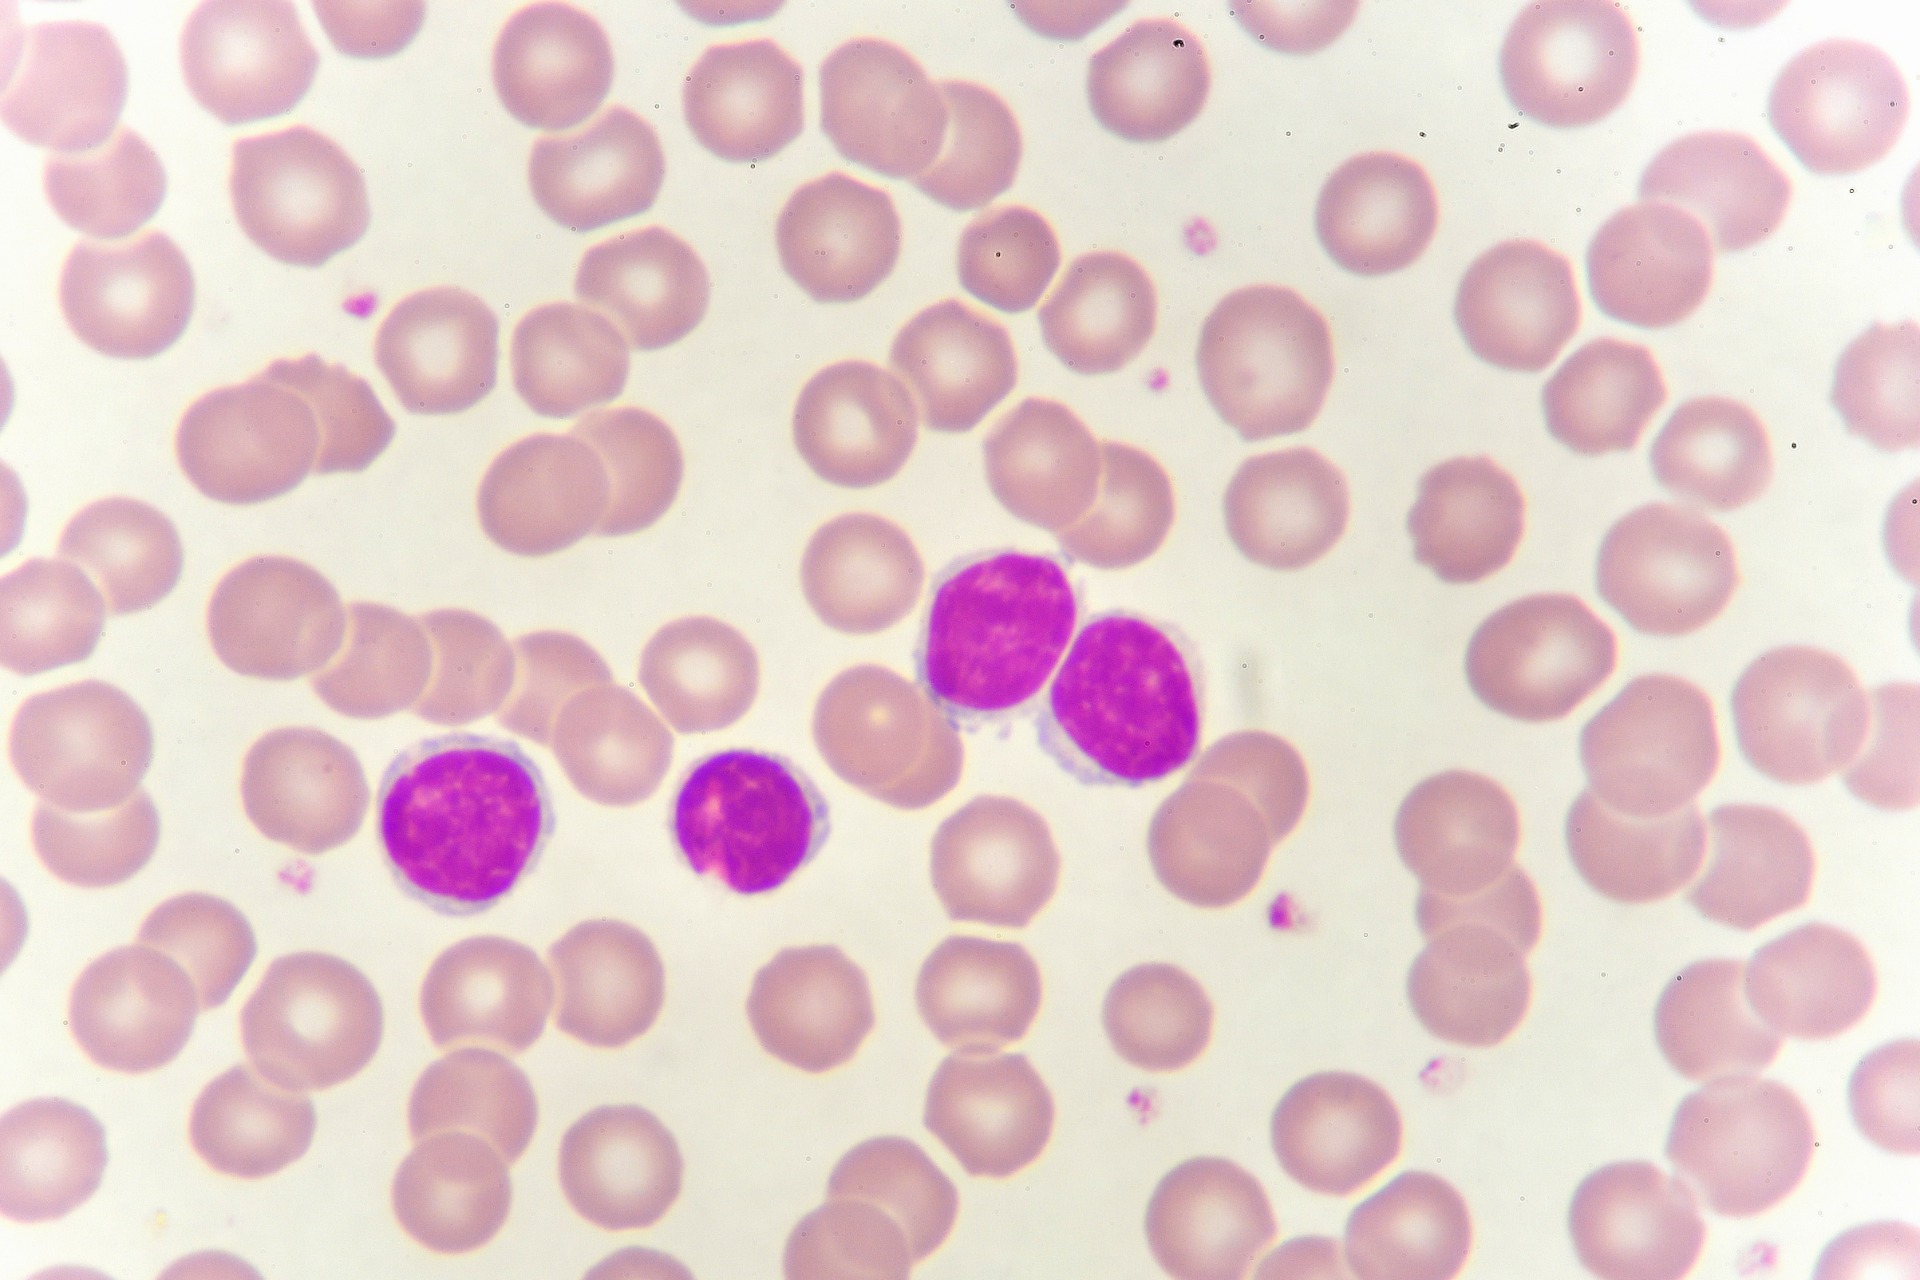

최근 인기 절정인 넷플릭스 드라마 ‘폭싹 속았수다’에서 양관식(배우 박보검,박해준 분)이 진단받은 병이 류마티스 관절염이 아닌 ‘다발성 골수종’으로 밝혀지면서, 해당 질환에 대한 관심이 높아지고 있다.
혈액세포는 백혈구, 적혈구, 혈소판으로 이루어져 있으며, 그중 백혈구는 우리 몸의 면역을 담당하고 있다. 백혈구의 한 종류인 림프구에 항체를 분비하는 형질세포가 비정상적으로 증식하는 병이 바로 다발성 골수종이다.
다발성 골수종은 국내에서도 고령 인구 증가와 함께 환자 수가 꾸준히 늘고 있다. 국립암센터 국가암정보센터에 따르면, 국내 환자 수는 2010년 약 1,000명에서 2020년 약 2,500명 이상으로 2배 이상 증가했다. 특히 65세 이상 환자가 전체의 60% 이상을 차지해, 고령화 사회 주요 혈액암으로 주목된다.
다발성 골수종은 대부분 65세 이상 고령층에서 발병하며, 고칼슘혈증(피로감, 구토, 혼수), 신기능 이상(소변감소, 신부전), 빈혈(만성피로, 창백함), 뼈 침범 (지속적인 뼈 통증, 병적 골절) 등 4가지 주요 증상을 동반한다. 그 밖에는 무증상인 경우도 많다.
다발성 골수종인 경우 비정상적으로 변한 형질세포가 비정상적인 항체 단백질을 생성하는데 이 항체 단백질을 보통 M단백이라고 한다. 혈액 또는 소변 검사로 M단백 존재를 확인하고 골수검사에서 형질세포 증가가 확인되면 다발성 골수종으로 진단한다. 이 밖에도 뼈 조직검사에서 형질세포종양을 확인하여 진단할 수 있다.
예후는 병기에 따라 크게 다르다. 예후 지표에 따른 생존율을 살펴보면 1기, 2기 및 3기로 나누게 된다. 예후가 좋다면 5년 생존율은 80%에 달한다. 평균 생존 기간은 1기는 10년 이상, 2기와 3기는 각각 7년과 3년 정도이다. 따라서 예후지표가 좋다면 장기 생존이 가능한 만성질환으로 관리 가능하며, 치료법은 환자 나이와 건강 상태에 따라 결정된다.
무증상 환자는 3개월에서 6개월 간격으로 주기적 관찰로 체크하며 증상이 있는 다발성 골수종은 항암치료를 해야 한다. 만약 70세 이하이고 체력이 양호하면 자가조혈모세포 이식을 통해 완치를 기대할 수 있다. 70세 이상 고령은 자가조혈모세포 이식이 대부분 불가능해 주로 항암제 2제 혹은 3제 요법으로 치료하게 된다.
<저작권자 ⓒ 헬스위크, 무단 전재 및 재배포 금지>
이예숙 기자 다른기사보기





